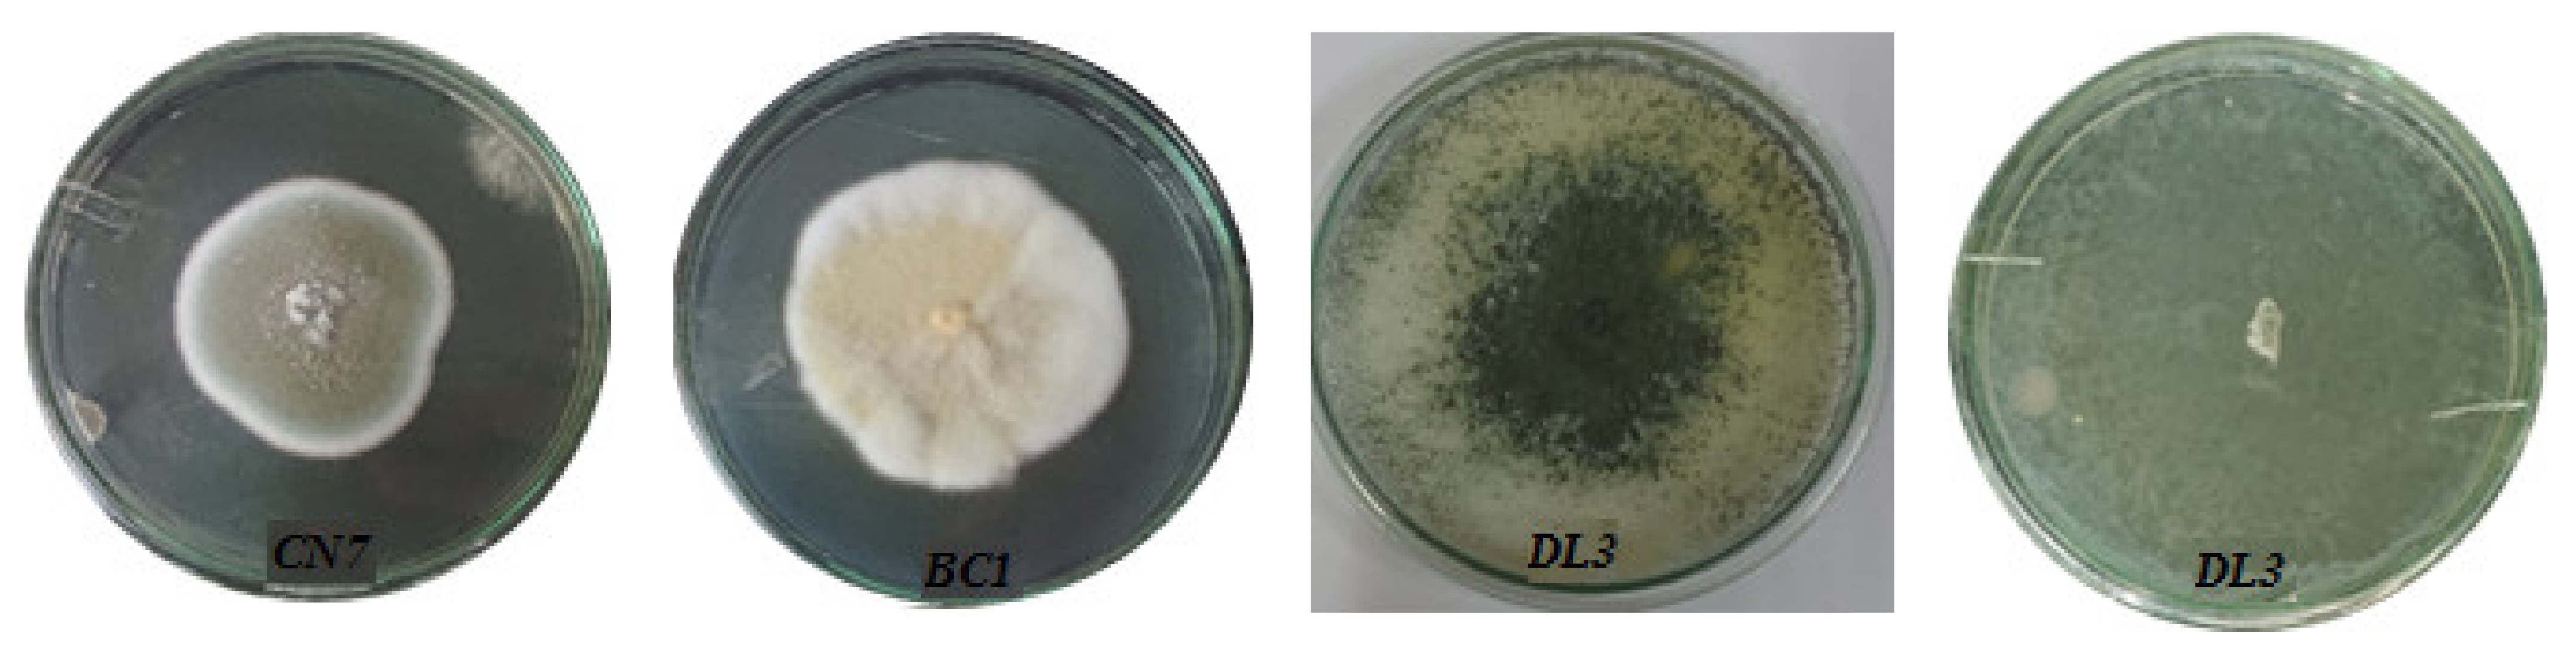
Molecules 27 05051 g003 Molecules 27 05051 g003
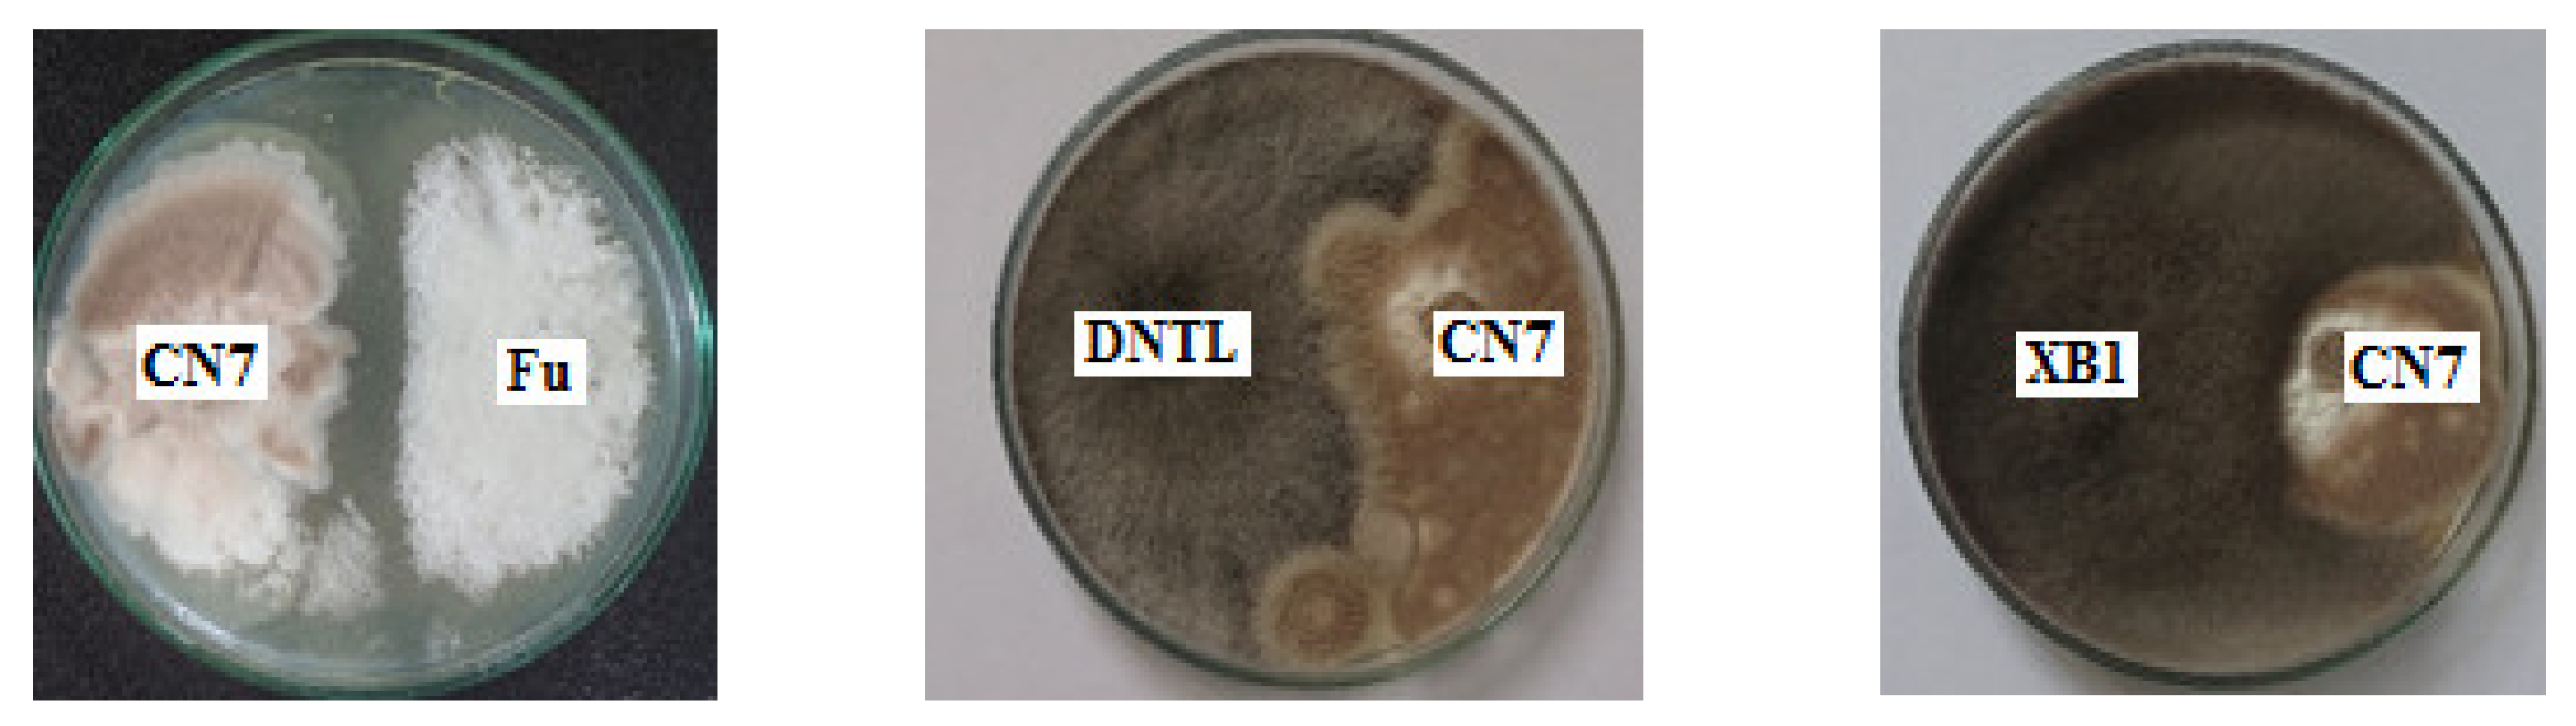
Molecules 27 05051 g004a Molecules 27 05051 g004a
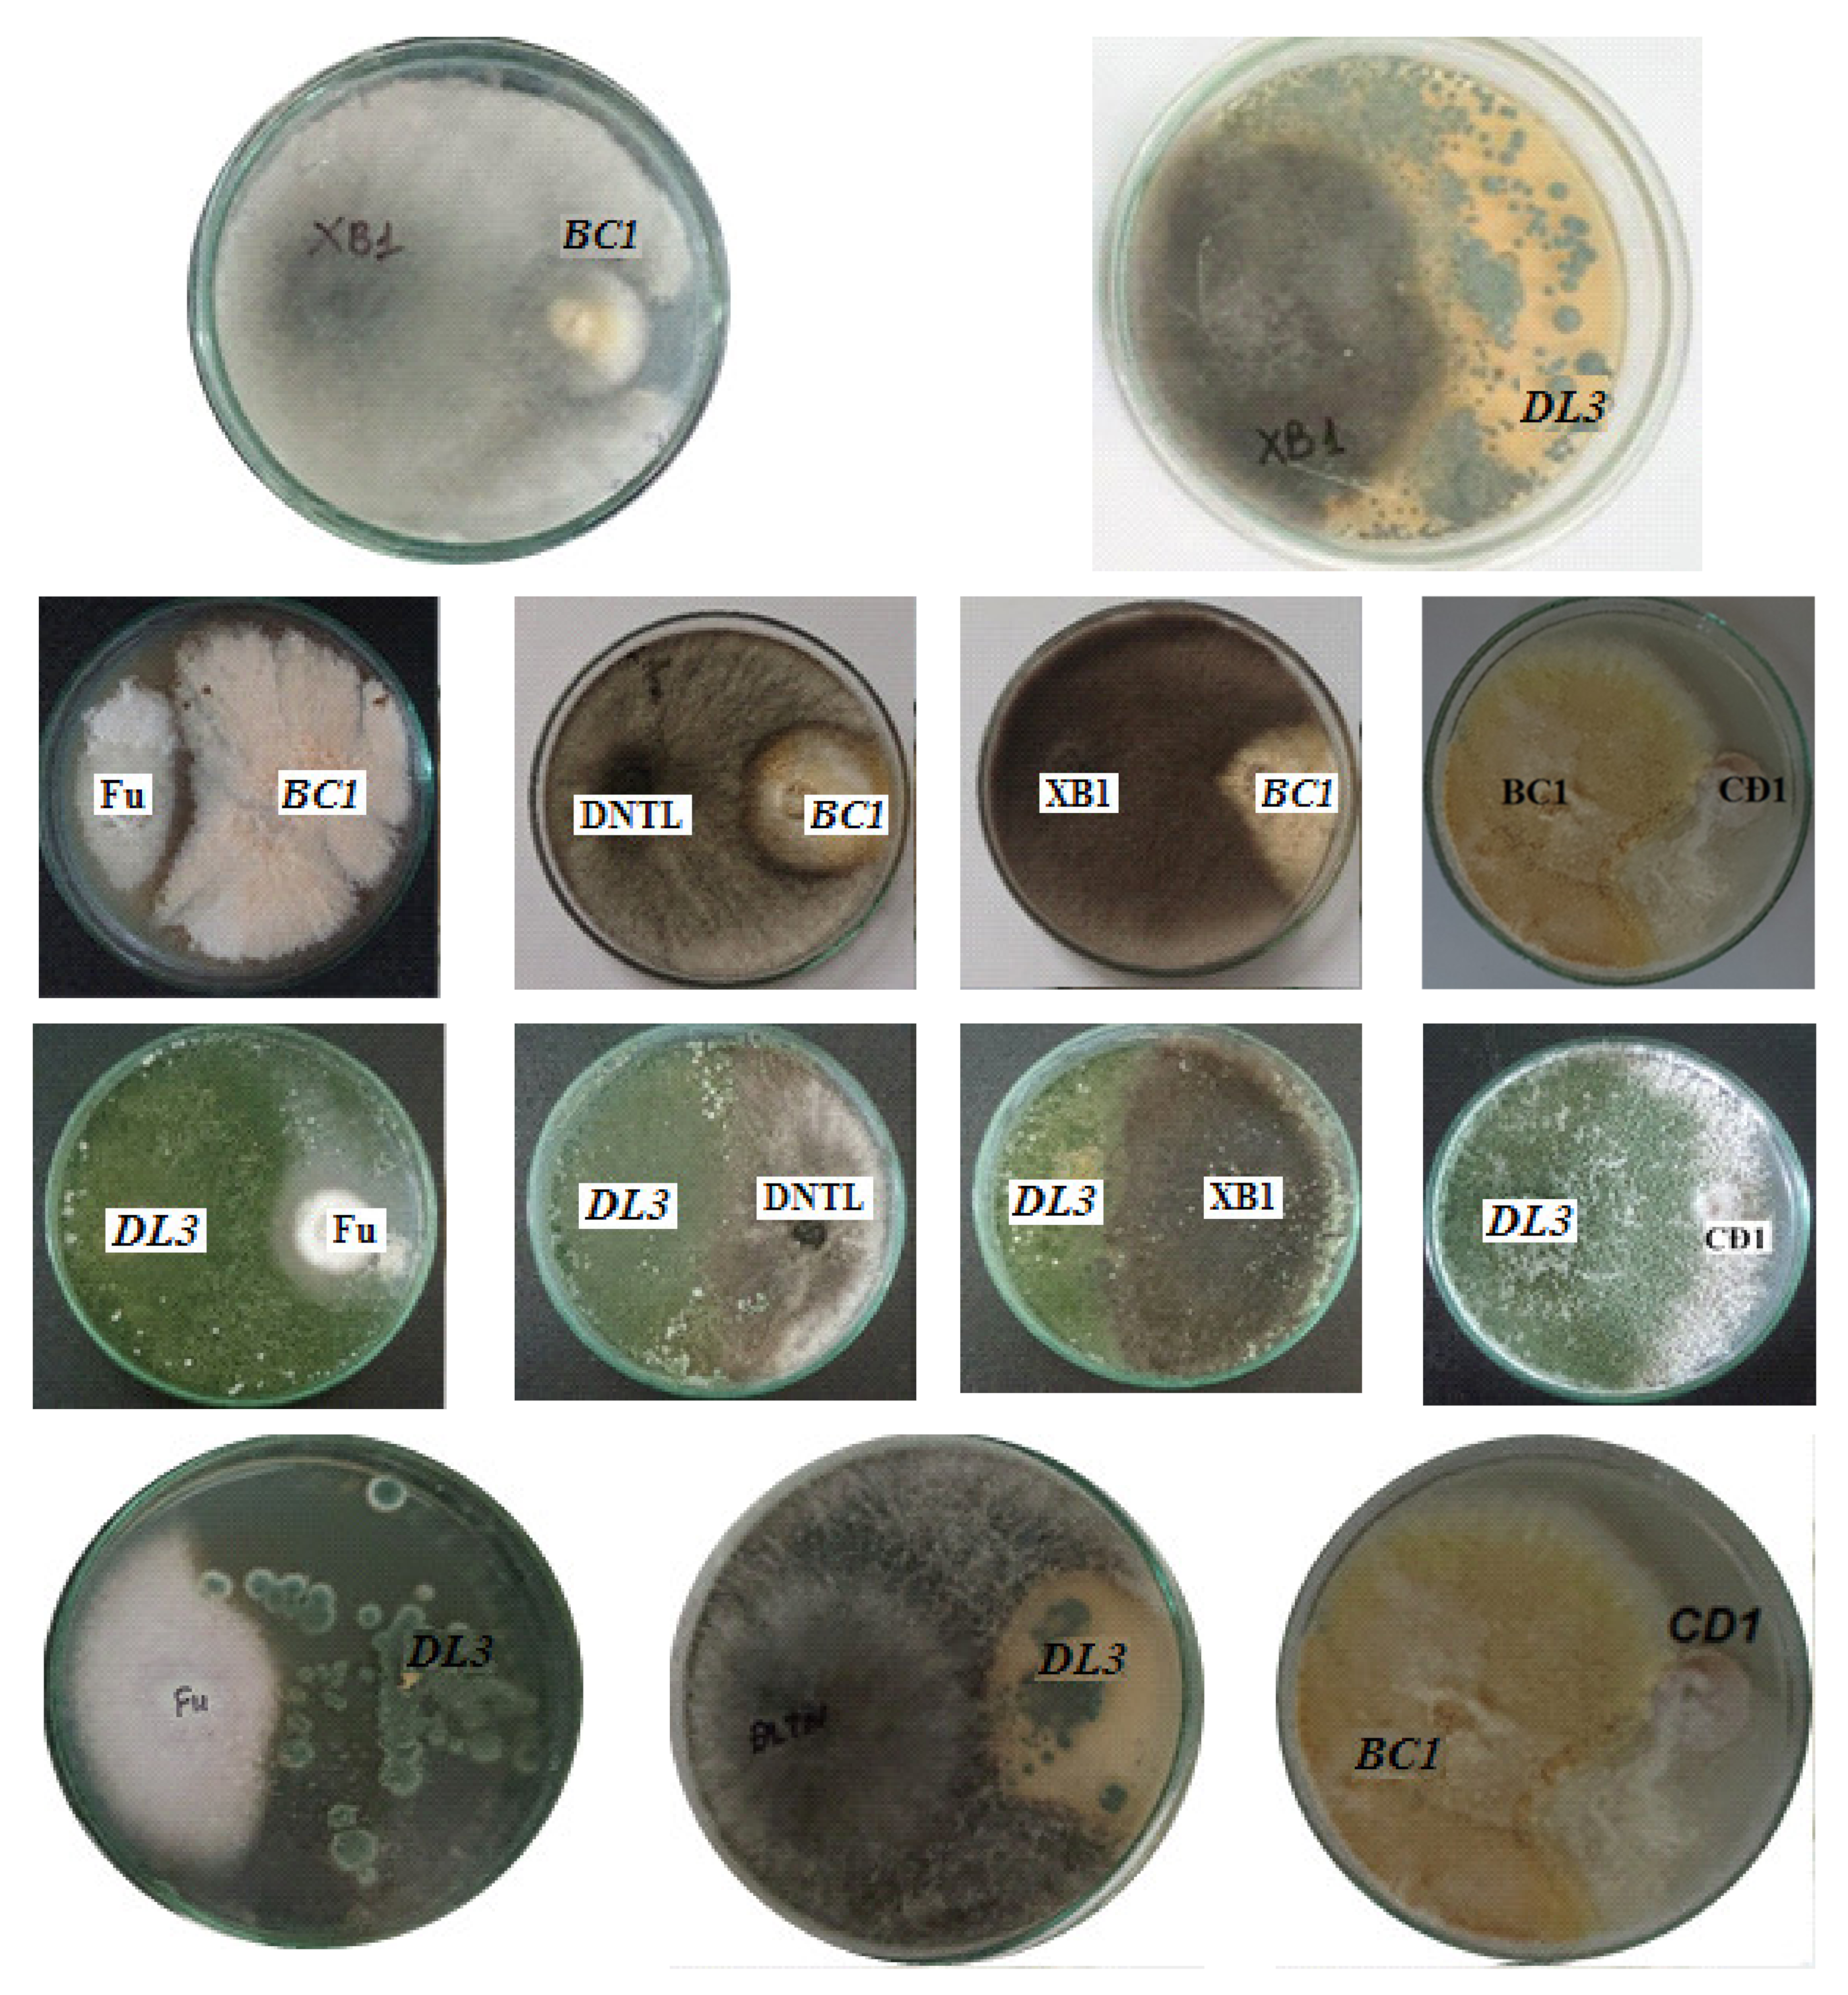
Molecules 27 05051 g004b Molecules 27 05051 g004b

Growth Stimulation, Phosphate Resolution, and Resistance to Fungal Pathogens of Some Endogenous Fungal Strains in the Rhizospheres of Medicinal Plants in Vietnam
Abstract
1. Introduction
2. Results and Discussion
2.1. Identification of Most Potent Endophytic Fungal Strains
2.2. Growth Dynamics of Fungal Strains
2.3. Filamentous Propagation of Fungal Strains
2.4. Antagonistic Activity against Pathogenic Fungi
3. Materials and Methods
3.1. Materials
3.2. Methods
3.2.1. Isolation of Endophytic Fungal Strains
3.2.2. Determination of Phosphate-Solubilizing Activity
3.2.3. Analysis of Indole Acetic Acid Content
3.2.4. Morphological and Growth Characteristics
3.2.5. Determination of Antifungal Activity
3.2.6. Molecular Identification
4. Conclusions
Author Contributions
Funding
Institutional Review Board Statement
Informed Consent Statement
Data Availability Statement
Acknowledgments
Conflicts of Interest
Sample Availability
References
- Ahmed, M.E.; Amr, F.; Mohamed, A.A.-R.; Salem, S.S.; Albaraa, E.; Ralf, O.; Mohamed, H.; Arnab, B.; Amr, E.; Saad, E.-D.H. Harnessing Bacterial Endophytes for Promotion of Plant Growth and Biotechnological Applications: An Overview. Plants 2021, 10, 935. [Google Scholar]
- Hany, A.M.M.; Amr, F.; Ahmed, M.E.; Emad, E.-D.E.; Saad, E.-D.H. Biotechnological application of plant growth-promoting endophytic bacteria isolated from halophytic plants to ameliorate salinity tolerance of Vicia faba L. Plant Biotechnol. Rep. 2021, 15, 819–843. [Google Scholar]
- Oanh, H.H.; Quynh, T.T.T.; Dieu-Thuong, T.T.; Van-Dan, N.; Duc, P.N.D.; Triet, T.N. A Review of Traditional Uses, Phytochemistry and Pharmacological Properties of Some Vietnamese Wound-Healing Medicinal Plants. Nat. Prod. Commun. 2022, 17, 1–11. [Google Scholar]
- Hanh, M.T.; Dung, T.T.N.; Ngan, T.M.; Hien, T.D.; Thanh, K.T.N.; Thao, K.N.N.; Marc, M.; Huy, Q.N.; Hai, T.P. Notes on Culturable Endophytic Microorganisms Isolated from 14 Medicinal Plants in Vietnam: A Diversity Analysis to Predict the Host-Microbe Correlations. Curr. Microbiol. 2022, 79, 140. [Google Scholar]
- Mehta, P.; Sharma, R.; Putatunda, C.; Walia, A. Endophytic fungi: Role in phosphate solubilization. In Multi-Stage and Multi-Time Scale Feedback Control of Linear Systems with Applications to Fuel Cells; Singh, B.P., Ed.; Springer Nature Switzerland AG: Cham, Switzerland, 2019; pp. 183–209. [Google Scholar]
- Poveda, J. Beneficial effects of microbial volatile organic compounds (MVOCs) in plants. Appl. Soil Ecol. 2021, 168, 104118. [Google Scholar] [CrossRef]
- Poveda, J.; Abril-Urias, P.; Escobar, C. Biological control of plant-parasitic nematodes by filamentous fungi inducers of resistance: Trichoderma, Mycorrhizal and endophytic fungi. Front. Microbiol. 2020, 11, 992. [Google Scholar] [CrossRef]
- Cui, R.; Lu, X.; Chen, X.; Malik, W.A.; Wang, D.; Wang, J.; Wang, S.; Guo, L.; Chen, C.; Wang, X.; et al. A novel raffinose biological pathway is observed by symbionts of cotton=Verticillium dahliae to improve salt tolerance genetically on cotton. J. Agron. Crop Sci. 2021, 207, 956–969. [Google Scholar] [CrossRef]
- Hunt, M.G.; Newman, J.A. Reduced herbivore resistance from a novel grass-endophyte association. J. Appl. Ecol. 2005, 42, 762–769. [Google Scholar] [CrossRef]
- Rodriguez, R.; Redman, R. More than 400 million years of evolution and some plants still can’t make it on their own: Plant stress tolerance via fungal symbiosis. J. Exp. Bot. 2008, 59, 1109–1114. [Google Scholar] [CrossRef]
- Mejia, L.C.; Herre, E.A.; Sparks, J.P.; Winter, K.; Garcia, M.N.; Van Bael, S.A.; Stitt, J.; Shi, Z.; Zhang, Y.; Guiltinan, M.J.; et al. Pervasive effects of a dominant foliar endophytic fungus on host genetic and phenotypic expression in a tropical tree. Front. Microbiol. 2014, 5, 479. [Google Scholar] [CrossRef]
- Hardoim, P.R.; Van Overbeek, L.S.; Van Elsas, J.D. Properties of bacterial endophytes and their proposed role in plant growth. Trends Microbiol. 2008, 16, 463–471. [Google Scholar] [CrossRef]
- Sujit, S.; Roshani, S.; Sabitri, M.; Marc-Andre, S.; Bijaya, P. Isolation and Characterization of Plant Growth-Promoting Endophytic Fungi from the Roots of Dendrobium moniliform. Plants 2019, 8, 5. [Google Scholar]
- Bhattacharyya, P.N.; Jha, D.K. Plant growth-promoting rhizobacteria (PGPR): Emergence in agriculture. World J. Microbiol. Biotechnol. 2012, 28, 1327–1350. [Google Scholar] [CrossRef]
- Avdalović, J.; Beškoski, V.; Gojgić-Cvijović, G.; Mattinen, M.-L.; Stojanović, M.; Zildžović, S. Microbial solubilization of phosphorus from phosphate rock by iron-oxidizing Acidithiobacillus sp. B2. Miner. Eng. 2015, 72, 17–22. [Google Scholar] [CrossRef]
- Cakmak, I. Enrichment of cereal grains with zinc: Agronomic or genetic biofortification? Plant Soil 2008, 302, 1–17. [Google Scholar] [CrossRef]
- Widowati, T.; Putrie, R.F.W.; Lekatompessy, S.J.; Sukiman, H. Peningkatan galur pada bakteri penghasil IAA yang diisolasi dari bintil akar tanaman turi (Strain Improvement on Iaaproducing Bacteria Isolated From Root Nodules of Sesbania grandiflora (L)). Biopropal Ind. 2018, 9, 71–77. [Google Scholar]
- Bischof, R.H.; Jonas, R.; Bernhard, S. Cellulases and beyond: The first 70 years of the enzyme producer Trichoderma reesei. Microb. Cell Fact. 2016, 15, 106. [Google Scholar] [CrossRef]
- Ahmed, M.A.K.; Saad, E.-D.H.; Sultan, M.A.; Ahmed, M.E.; Emad, E.-D.E.; Ehab, A.; Adil, A.G.; Amr, E.; Amr, F. Isolation and Characterization of Fungal Endophytes Isolated from Medicinal Plant Ephedra pachyclada as Plant Growth-Promoting. Biomolecules 2021, 11, 140. [Google Scholar]
- Hassan, S.E.-D.; Fouda, A.; Radwan, A.A.; Salem, S.S.; Barghoth, M.G.; Awad, M.A.; Abdo, A.M.; El-Gamal, M.S. Endophytic actinomycetes Streptomyces spp. mediated biosynthesis of copper oxide nanoparticles as a promising tool for biotechnological applications. Jbic J. Biol. Inorg. Chem. 2019, 24, 377–393. [Google Scholar] [CrossRef]
- Hassan, S.E.-D.; Salem, S.S.; Fouda, A.; Awad, M.A.; El-Gamal, M.S.; Abdo, A.M. New approach for antimicrobial activity and bio-control of various pathogens by biosynthesized copper nanoparticles using endophytic actinomycetes. J. Radiat. Res. Appl. Sci. 2018, 11, 262–270. [Google Scholar] [CrossRef]
- Felde, Z.A.; Pocasangre, L.E.; Carnizares Monteros, C.A.; Sikora, R.A.; Rosales, F.E.; Riveros, A.S. Effect of combined inoculations of endophytic fungi on the biocontrol of Radopholus similis. InfoMusa 2006, 15, 12–18. [Google Scholar]
- Tamanreet, K. Fungal Endophyte-Host Plant Interactions: Role in Sustainable Agriculture. In Sustainable Crop Production; IntechOpen: London, UK, 2020; pp. 1–18. [Google Scholar]
- Naraghi, L.; Heydari, A.; Rezaee, S.; Razavi, M. Biocontrol Agent Talaromyces flavus Stimulates the Growth of Cotton and Potato. J. Plant Growth Regul. 2012, 31, 471–477. [Google Scholar] [CrossRef]
- Patil, P.M.; Kuligod, V.; Hebsur, N.; Patil, C.; Kulkarni, G. Effect of phosphate solubilizing fungi and phosphorus levels on growth, yield and nutrient content in maize (Zea mays). Karnataka J. Agric. Sci. 2012, 25, 58–62. [Google Scholar]
- Li, Z.; Bai, T.; Dai, L.; Wang, F.; Tao, J.; Meng, S.; Hu, Y.; Wang, S.; Hu, S. A study of organic acid production in contrasts between two phosphate solubilizing fungi: Penicillium oxalicum and Aspergillus niger. Sci. Rep. 2016, 6, 25313. [Google Scholar] [CrossRef]
- Singh, H.; Reddy, M.S. Effect of inoculation with phosphate solubilizing fungus on growth and nutrient uptake of wheat and maize plants fertilized with rock phosphate in alkaline soils. Eur. J. Soil Biol. 2011, 47, 30–34. [Google Scholar] [CrossRef]
- Din, M.; Nelofer, R.; Salman, M.; Abdullah; Khan, F.H.; Khan, A.; Ahmad, M.; Jalil, F.; Din, J.U.; Khan, M. Production of nitrogen fixing Azotobacter (SR-4) and phosphorus solubilizing Aspergillus niger and their evaluation on Lagenaria siceraria and Abelmoschus esculentus. Biotechnol. Rep. 2019, 22, e00323. [Google Scholar] [CrossRef]
- Malviya, J.; Singh, K.; Joshi, V. Effect of phosphate solubilizing fungi on growth and nutrient uptake of ground nut (Arachis hypogaea) plants. Adv. Biores. 2011, 2, 110–113. [Google Scholar]
- Jain, R.; Saxena, J.; Sharma, V. Effect of phosphate-solubilizing fungi Aspergillus awamori S29 on mungbean (Vigna radiata cv. RMG 492) growth. Folia Microbiol. 2012, 57, 533–541. [Google Scholar] [CrossRef]
- Ram, H.; Malik, S.; Dhaliwal, S.; Kumar, B.; Singh, Y. Growth and productivity of wheat affected by phosphorus-solubilizing fungi and phosphorus levels. Plant Soil Environ. 2015, 61, 122–126. [Google Scholar] [CrossRef]
- Gizaw, B.; Tsegay, Z.; Tefera, G.; Aynalem, E.; Wassie, M.; Abatneh, E. Phosphate solubilizing fungi isolated and characterized from Teff rhizosphere soil collected from North Showa zone, Ethiopia. Afr. J. Microbiol. Res. 2017, 11, 687–696. [Google Scholar]
- Zhang, Y.; Chen, F.-S.; Wu, X.-Q.; Luan, F.-G.; Zhang, L.-P.; Fang, X.-M.; Wan, S.-Z.; Hu, X.-F.; Ye, J.-R. Isolation and characterization of two phosphate-solubilizing fungi from rhizosphere soil of moso bamboo and their functional capacities when exposed to different phosphorus sources and pH environments. PLoS ONE 2018, 13, e0199625. [Google Scholar]
- Bononi, L.; Chiaramonte, J.B.; Pansa, C.C.; Moitinho, M.A.; Melo, I.S. Phosphorus-solubilizing Trichoderma spp. from Amazon soils improve soybean plant growth. Sci. Rep. 2020, 10, 2858. [Google Scholar] [CrossRef] [PubMed]
- Babu, A.G.; Kim, S.W.; Yadav, D.R.; Hyum, U.; Adhikari, M.; Lee, Y.S. Penicillium menonorum: A novel fungus to promote growth and nutrient management in cucumber plants. Mycobiology 2015, 43, 49–56. [Google Scholar] [CrossRef] [PubMed]
- Silva-Mendoza, J.; Gómez-Treviño, A.; López-Chuken, U.; Blanco-Gámez, E.A.; Chávez-Guerrero, L.; Cantú-Cárdenas, M.E. Agave Leaves as a Substrate for the Production of Cellulases by Penicillium sp. and the Obtainment of Reducing Sugars. J. Chem. 2020, 2020, 6092165. [Google Scholar] [CrossRef]
- He, R.; Ding, R.; Heyman, J.A.; Zhang, D.; Tu, R. Ultra-high-throughput picoliter-droplet microfluidics screening of the industrial cellulase-producing filamentous fungus Trichoderma reesei. J. Ind. Microbiol. Biotechnol. 2019, 46, 1603–1610. [Google Scholar] [CrossRef]
- Linke, R.; Thallinger, G.G.; Haarmann, T.; Eidner, J.; Schreiter, M.; Lorenz, P.; Seiboth, B.; Kubicek, C.P. Restoration of female fertility in Trichoderma reesei QM6a provides the basis for inbreeding in this industrial cellulase producing fungus. Biotechnol. Biofuels 2015, 8, 155. [Google Scholar] [CrossRef]
- Subramanian, V.; Schuster, L.A.; Moore, K.T.; Taylor, I.I.; Larry, E.; Baker, J.O.; Vander, W.; Todd, A.; Linger, J.G.; Himmel, M.E.; et al. A versatile 2A peptide-based bicistronic protein expressing platform for the industrial cellulase producing fungus, Trichoderma reesei. Biotechnol. Biofuels 2017, 10, 34. [Google Scholar] [CrossRef]
- Banu, A.R.; Devi, M.K.; Gnanaprabhal, G.; Pradeep, B.; Palaniswamy, M. Production and characterization of pectinase enzyme from Penicillium chrysogenum. Indian J. Sci. Technol. 2010, 3, 377–381. [Google Scholar] [CrossRef]
- Li, Y.; Cui, F.; Liu, Z.; Xu, Y.; Zhao, H. Improvement of xylanase production by Penicillium oxalicum ZH-30 using response surface methodology. Enzym. Microb. Technol. 2007, 40, 1381–1388. [Google Scholar] [CrossRef]
- Lee, S.H.; Hosseindoust, A.; Laxman, I.S.; Rathi, P.C.; Yoon, S.Y.; Choi, J.W. Thermostable xylanase derived from Trichoderma citrinoviride increases growth performance and non-starch polysaccharide degradation in broiler chickens. British Poult. Sci. 2020, 61, 57–62. [Google Scholar] [CrossRef]
- Gajera, H.; Katakpara, Z.A.; Patel, S.; Golakiya, B. Antioxidant defense response induced by Trichoderma viride against Aspergillus niger Van Tieghem causing collar rot in groundnut (Arachis hypogaea L.). Microb. Pathog. 2016, 91, 26–34. [Google Scholar] [CrossRef]
- Ribeiro, S.F.L.; da Costa, G.; dos Santos, H.E.D.; Montoya, Q.V.; Rodrigues, A.; de Oliveira, J.M.; de Oliveira, C.M. Antimicrobial activity of crude extracts of endophytic fungi from Oryctanthus alveolatus (Kunth) Kuijt (Mistletoe). Afr. J. Microbiol. Res. 2018, 12, 263–268. [Google Scholar]
- Iswarya, B.; Ramesh, K.V. Promising Antimicrobial Compounds from an Endophytic Fungus Penicillium daleae EF 4 Isolated from the Seaweed Enteromorpha flexuosa Linn. Res. Rev. A J. Microbiol. Virol. 2019, 9, 26–39. [Google Scholar]
- Radhakrishnan, R.; Kang, S.-M.; Baek, I.-Y.; Lee, I.-J. Characterization of plant growth-promoting traits of Penicillium species against the effects of high soil salinity and root disease. J. Plant Interact. 2014, 9, 754–762. [Google Scholar] [CrossRef]
- Alam, S.S.; Sakamoto, K.; Inubushi, K. Biocontrol efficiency of Fusarium wilt diseases by a root-colonizing fungus Penicillium sp. Soil Sci. Plant Nut. 2011, 57, 204–212. [Google Scholar] [CrossRef]
- Ting, A.S.Y.; Mah, S.W.; Tee, C.S. Evaluating the feasibility of induced host resistance by endophytic isolate Penicillium citrinum BTF08 as a control mechanism for Fusarium wilt in banana plantlets. Biol. Control 2012, 61, 155–159. [Google Scholar] [CrossRef]
- Nielson, M.N.; Sorensen, J.; Fels, J.; Pdersen, H.C. Secondary metabolite and endochitinase dependent antagonism toward plant pathogenic microfungi of Pseudomonas fluorescens isolates from sugar beet rhizosphere. Appl. Environ. Microbiol. 1998, 64, 3563–3569. [Google Scholar] [CrossRef]
- Farias, C.P.; Carvalho, R.C.; Resende, F.M.; Azevedo, L.C. Consortium of five fungal isolates conditioning root growth and arbuscular mycorrhiza in soybean, corn, and sugarcane. An. Acad. Bras. CieNcias 2018, 90, 3649–3660. [Google Scholar] [CrossRef]
- Thomas, M.B.; Read, A.F. Fungal bioinsecticide with a sting. Nat. Biotechnol. 2007, 25, 1367–1368. [Google Scholar] [CrossRef]
- De Silva, N.I.; Brooks, S.; Lumyong, S.; Hyde, K.D. Use of endophytes as biocontrol agents. Fungal Biol. Rev. 2019, 33, 133–148. [Google Scholar] [CrossRef]
- Hajji-Hedfi, L.; Regaieg, H.; Larayedh, A.; Chihani, N.; Horrigue-Raouani, N. Biological control of wilt disease complex on tomato crop caused by Meloidogyne javanica and Fusarium oxysporum f. sp. lycopersici by Verticillium leptobactrum. Environ. Sci. Pollut. Res. 2018, 25, 18297–18302. [Google Scholar] [CrossRef]
- Larran, S.; Simon, M.R.; Moreno, M.V.; Siurana, M.S.; Perelló, A. Endophytes from wheat as biocontrol agents against tan spot disease. Biol. Control 2016, 92, 17–23. [Google Scholar] [CrossRef]
- Tranier, M.-S.; Pognant-Gros, J.; Quiroz, R.D.l.C.; González, C.N.A.; Mateille, T.; Roussos, S. Commercial biological control agents targeted against plant-parasitic root-knot nematodes. Braz. Arch. Biol. Technol. 2014, 57, 831–841. [Google Scholar] [CrossRef]
- Singh, V.K.; Singh, M.; Singh, S.K.; Kumar, C.; Kumar, A. Sustainable Agricultural Practices Using Beneficial Fungi Under Changing Climate Scenario. In Climate Change and Agricultural Ecosystems; Choudhary, K.K., Kumar, A., Singh, A.K., Eds.; Elsevier Woodhead Publishing: Cambridge, UK, 2019; pp. 25–42. [Google Scholar]
- Watanabe, F.; Olsen, S. Test of an ascorbic acid method for determining P in water and NaHCO3 extracts from soil. Soil Sci. Soc. Am. J. 1965, 29, 677–678. [Google Scholar] [CrossRef]
- Brick, J.M.; Bostock, R.M.; Silversone, S.E. Rapid in situ assay for indole acetic acid production by bacteria immobilization on a nitrocellulose membrane. Appl. Environ. Microbiol. 1991, 57, 535–538. [Google Scholar] [CrossRef]
- Schwantes, H.O.; Salttler, P.W. Methoden zur messung der Wachstumsgeschwindigkeit von Pilzmycelien. Oberhess. Nat. Z. 1971, 38, 5–18. [Google Scholar]
- Zhang, Q.; Zhang, J.; Yang, L.; Zhang, L.; Jiang, D.; Chen, W.; Li, G. Diversity and biocontrol potential of endophytic fungi in Brassica napus. Biol. Control 2014, 72, 98–108. [Google Scholar] [CrossRef]
- Sambrook, J.; Russell, D.W. Molecular cloning. In A Laboratory Manual, 3rd ed.; Cold Spring Harbor Laboratory: New York, NY, USA, 2001. [Google Scholar]
- Gardes, M.; Bruns, T.D. ITS primers with enhanced specificity for basidiomycetes—Application to the identification of mycorrhizae and rusts. Mol. Ecol. 1993, 2, 113–118. [Google Scholar] [CrossRef]

| No | Mycorrhizal Plant | Strains | Colony Color | Pigment Secretion by the Phytopathogen |
|---|---|---|---|---|
| 1 | Stevia rebaudiana (Bert.) Hemsl | CN1 | White-blue | Bright yellow color |
| 2 | CN2 | Gray | None | |
| 3 | CN3 | White | None | |
| 4 | CN4 | White | None | |
| 5 | CN5 | Green | Purple | |
| 6 | CN6 | Green, clustered | Yellow | |
| 7 | CN7 | Light black | None | |
| 8 | Polyscias fruticosa | DL1 | Black | None |
| 9 | DL2 | Black, cotton | None | |
| 10 | DL3 | White, cotton | None | |
| 11 | DL4 | Black | None | |
| 12 | DL5 | Yellow, cotton, clustered | Yellow | |
| 13 | DL6 | Black, even bacteriophage | None | |
| 14 | DL7 | Grizzle | None | |
| 15 | DL8 | White, thin yarn | None | |
| 16 | DL9 | White, yellow, brown thin | None | |
| 17 | DL10 | Light black | None | |
| 18 | DL11 | White short yarn | Yellow | |
| 19 | Angelica dahurica | BC1 | Gray | None |
| 20 | BC2 | Dark yellow | Yellow | |
| 21 | BC3 | White yarn | None | |
| 22 | BC4 | White yarn | None | |
| 23 | BC5 | White yarn, crowd | None | |
| 24 | BC6 | White yarn, cluster, hard | None | |
| 25 | BC7 | White grow cluster, smooth surface | None | |
| 26 | BC8 | White and yellow yarn cotton | None | |
| 27 | BC9 | Light pink-white yarn | None |
| No | Mycorrhizal Plant | Strains | Phosphatase Activities (D-d, mm) |
|---|---|---|---|
| 1 | Stevia rebaudiana (Bert.) Hemsl | CN1 | 0 |
| 2 | CN2 | 0 | |
| 3 | CN3 | 7 | |
| 4 | CN4 | 0 | |
| 5 | CN5 | 14 | |
| 6 | CN6 | 0 | |
| 7 | CN7 | 12 | |
| 8 | Polyscias fruticosa | DL1 | 11 |
| 9 | DL2 | 0 | |
| 10 | DL3 | 12 | |
| 11 | DL4 | 9 | |
| 12 | DL5 | 0 | |
| 13 | DL6 | 15 | |
| 14 | DL7 | 0 | |
| 15 | DL8 | 7 | |
| 16 | DL9 | 0 | |
| 17 | DL10 | 0 | |
| 18 | DL11 | 5 | |
| 19 | Angelica dahurica | BC1 | 10 |
| 20 | BC2 | 0 | |
| 21 | BC3 | 0 | |
| 22 | BC4 | 11 | |
| 23 | BC5 | 0 | |
| 24 | BC6 | 14 | |
| 25 | BC7 | 11 | |
| 26 | BC8 | 12 | |
| 27 | BC9 | 7 |
| Strains | Penicillium simplicissimum CN7 | Talaromyces flavus BC1 | Trichoderma konilangbra DL3 |
|---|---|---|---|
| The length of filament (µm/h) | 34.4 ± 2.09 | 43.88 ± 1.27 | 106.02 ± 1.60 |
Publisher’s Note: MDPI stays neutral with regard to jurisdictional claims in published maps and institutional affiliations. |
© 2022 by the authors. Licensee MDPI, Basel, Switzerland. This article is an open access article distributed under the terms and conditions of the Creative Commons Attribution (CC BY) license (https://creativecommons.org/licenses/by/4.0/).
Share and Cite
Huong, N.T.M.; Hoai, P.T.T.; Thao, P.T.H.; Huong, T.T.; Chinh, V.D. Growth Stimulation, Phosphate Resolution, and Resistance to Fungal Pathogens of Some Endogenous Fungal Strains in the Rhizospheres of Medicinal Plants in Vietnam. Molecules 2022, 27, 5051. https://doi.org/10.3390/molecules27165051
Huong NTM, Hoai PTT, Thao PTH, Huong TT, Chinh VD. Growth Stimulation, Phosphate Resolution, and Resistance to Fungal Pathogens of Some Endogenous Fungal Strains in the Rhizospheres of Medicinal Plants in Vietnam. Molecules. 2022; 27(16):5051. https://doi.org/10.3390/molecules27165051
Chicago/Turabian StyleHuong, Nguyen Thi Mai, Pham Thi Thu Hoai, Phan Thi Hong Thao, Tran Thi Huong, and Vu Duc Chinh. 2022. "Growth Stimulation, Phosphate Resolution, and Resistance to Fungal Pathogens of Some Endogenous Fungal Strains in the Rhizospheres of Medicinal Plants in Vietnam" Molecules 27, no. 16: 5051. https://doi.org/10.3390/molecules27165051
APA StyleHuong, N. T. M., Hoai, P. T. T., Thao, P. T. H., Huong, T. T., & Chinh, V. D. (2022). Growth Stimulation, Phosphate Resolution, and Resistance to Fungal Pathogens of Some Endogenous Fungal Strains in the Rhizospheres of Medicinal Plants in Vietnam. Molecules, 27(16), 5051. https://doi.org/10.3390/molecules27165051

